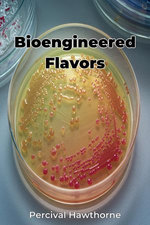
Bioengineered Flavors

Angus & Robertson is one of Australia's oldest and most iconic bookstores and since 1886 has been dedicated to delivering quality entertainment to the Australian public.
Our range includes millions of books, CDs, DVDs, audio books, gifts, stationery, games, eBooks and eReaders with over 100,000 products in stock and fast delivery Australia wide.
Thanks for supporting an Australian owned and operated business!
Displaying results 193-240 of
24,384
Epub (Kobo), Epub (Adobe)
Epub (Kobo), Epub (Adobe)
Epub (Kobo), Epub (Adobe)
Epub (Kobo), Epub (Adobe)
Epub (Kobo), Epub (Adobe)
Epub (Kobo), Epub (Adobe)
Epub (Kobo), Epub (Adobe)